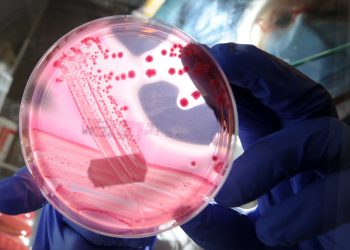
Resistência Microbiana: A Ameaça Global à Saúde

Vacina do Butantan contra Dengue Alcança 79% de Eficácia, Confirma Estudo no New England Journal of Medicine
A eficácia da vacina contra a dengue desenvolvida pelo Instituto Butantan foi oficialmente confirmada em um artigo publicado na quarta-feira, ...